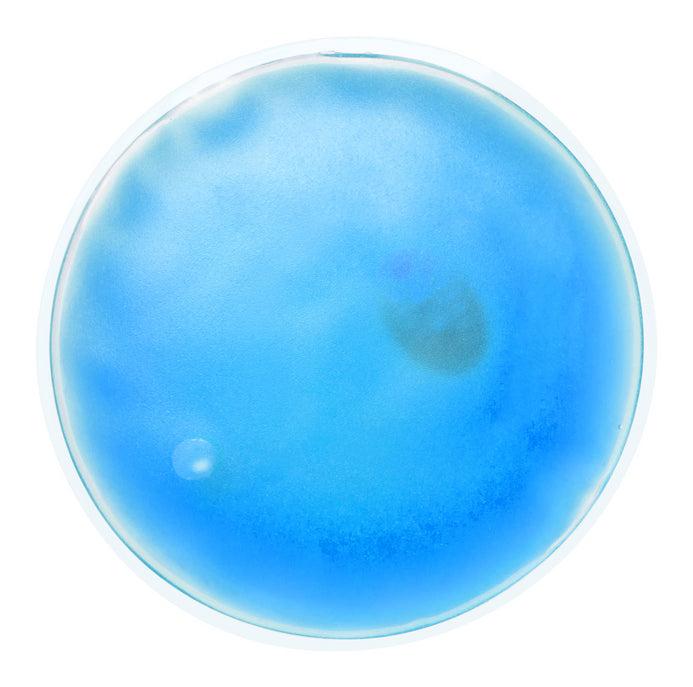

Compresă cald | AP781012-05
4,19 lei
Tu salvezi: (%)
Acest produs a fost vizualizat de ori în ultima oră
17 clienți vizualizează acest produs acum!
Disponibilitate: In stoc
Informații fiscale: Taxă inclusă.
Colectie: Articole medicale, Cel mai bine vândute, HOMEPAGE, New products, Vitalitate și îngrijire
Sku: AP781012-05
Vânzător: Kison
9:00 - 17:00 suport telefonic
Livrare în 3 - 5 zile lucrătoare!
Compresă reutilizabilă cald. Cu gel colorat.
| Informații despre produs | |
|---|---|
| Cod articol | AP781012 |
| Nume produs | compresă cald |
| Descriere | Compresă reutilizabilă cald. Cu gel colorat. |
| Culoare/culori | Red, Blue, Green, Pink, White, Yellow |
| Materiale | Plastic |
| Dimensiune | ø100×10 mm |
| Țara de origine | CN |
| Cod Unic de Înregistrare | 3926909790 |